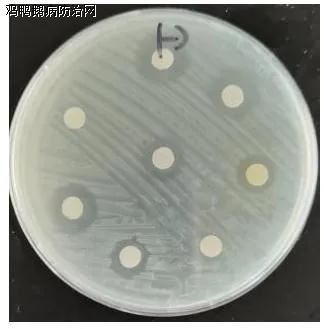

鸡鸭鹅病防治网联合驰骋中兽医研究所共同分享:
01、背景
潍坊市寒亭区某饲养户2021年8月购樱桃谷鸭10000只,22日龄时突然发病,死亡11只;次日发病107只,死亡42只。2天内发病率达13%,死亡率为5.3%,且有逐日增加趋势。在此期间曾用阿莫西林和粘杆菌素等药物治疗无效,第三天来华辰就诊。
02、临床症状
鸭突然发病,食欲废绝,闭目,缩颈呈犬坐式呆立。有些呈俯卧,嘴着地,两腿发软,不愿走动,眼眶湿润,鼻孔外侧可见浆膜性分泌物,排黄绿色稀粪。临死前多有神经症状,全身发抖,头向后仰呈角弓反张姿式。病程长者可见轻度咳嗽,转圈运动。逐渐消瘦、衰竭而死。
03、剖检病变
包心包肝,肺淤血,肾脏、脾脏、胰腺出血,个别鸭直肠轻微出血。如图所示:
04、实验室检测
1)细菌分离结果
无菌采取送检鸭肝脏分别涂布麦康凯平板和血平板,37℃培养过夜,在麦康凯平板上长有大量大肠杆菌,挑取血平板菌落革兰氏染色镜检,分离到鸭疫里默氏杆菌。如下图:
2)药敏试验结果
无菌取麦康凯平板和血平板上分离到的细菌,涂布MH平板,按箭头方向贴药敏纸片:普疾宁(氟苯尼考)、肠欣安(新霉素)、强力霉素、头孢、粘杆菌素、安普霉素。结果如下:
高敏药物:氟苯尼考、新霉素、安普霉素;中敏药物:强力霉素、粘杆菌素;不敏药物:头孢、阿莫西林。
3)PCR检测结果
图中1-3分别为送检鸭组织样品的ND(副粘病毒)、H9(禽流感)和DFV(黄病毒),M为DNA标志结果显示,送检鸭样品检测到H9亚型禽流感病毒,未检测到副粘病毒和黄病毒。最终确诊为H9亚型流感继发传染性浆膜炎与大肠杆菌病。

05、结果分析
送检鸭分离到大肠杆菌和鸭疫里默氏杆菌。药敏结果显示,高敏药物有氟苯尼考、新霉素和安普霉素。送检鸭检测到H9亚型禽流感病毒。
06、解决方案
做好流感疫苗的免疫,夏季不可不打流感油苗。根据药敏结果选用敏感药物普疾宁(氟苯尼考)、肠欣安(新霉素)等防治细菌感染,普疾宁1瓶100毫升兑100公斤水,或肠欣安1瓶100毫升兑200公斤水,或驰骋泰灭清1瓶100毫升兑300斤水,配合新力爽+驰骋芪贞颗粒,连用5天。加强饲养管理,注意舍内温度,饮水中添加生命核能,5天后大群恢复正常。
注:本文章来源于技术部。欢迎咨询参考。
鸡鸭鹅病防治网为规模化养殖企业(场)提供疫病防控最佳解决方案!!!
禽病实战专家咨询:13939028068 (技术总监-魏老师 个人 微信:CC-zbs 欢迎交流)博客http://blog.sina.com.cn/u/3862264327
养殖安、驰骋钙、新力爽等产品销售顾问:成龙在路上 13838248089 博客:http://blog.sina.com.cn/gallopschenglong
来源:鸡鸭鹅病防治网 http://www.jyebfz.com 中兽医 http://www.中兽医.com






发表评论共有0访客发表了评论
暂无评论,快来抢沙发吧!